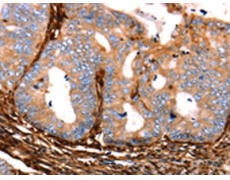
一抗

技術(shù)規(guī)格
Background:
The galectins are a family of beta-galactoside-binding proteins implicated in modulating cell-cell and cell-matrix interactions. This gene product may act as an autocrine negative growth factor that regulates cell proliferation. May regulate apoptosis, cell proliferation and cell differentiation. Binds beta-galactoside and a wide array of complex carbohydrates. Inhibits CD45 protein phosphatase activity and therefore the dephosphorylation of Lyn kinase.
Applications:
ELISA, WB, IHC
Name of antibody:
LGALS1
Immunogen:
Fusion protein of human LGALS1
Full name:
lectin, galactoside-binding, soluble, 1
Synonyms:
GBP, GAL1
SwissProt:
P09382
ELISA Recommended dilution:
1000-5000
IHC positive control:
Human cervical cancer and human esophagus cancer
IHC Recommend dilution:
25-100
WB Predicted band size:
15 kDa
WB Positive control:
Hela cells
WB Recommended dilution:
500-2000


 購物車
購物車 幫助
幫助
 021-54845833/15800441009
021-54845833/15800441009